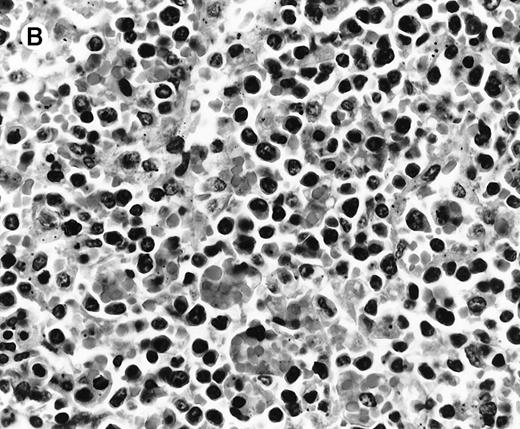
Fig. 1. Histologic findings in spleen. / (A) Section of spleen from case 2 shows depletion of white pulp and prominent sinusoidal small lymphoid infiltrates (hematoxylin and eosin, × 200). (B) The lymphocytes lack significant cytologic atypia. There is marked hemophagocytosis (hematoxylin and eosin, × 600).

Abstract
This study describes the clinicopathologic features of 5 patients who developed a fulminant Epstein-Barr virus (EBV)-positive clonal T-cell lymphoproliferative disorder (LPD) after acute EBV infection. One additional patient developed a similar disorder in the setting of long-standing chronic active EBV infection. Detailed immunophenotyping, in situ hybridization for EBV early RNA-1 (EBER1) and polymerase chain reaction (PCR) analyses for immunoglobulin (Ig) heavy chain and T-cell receptor (TCR)-gamma gene rearrangements were performed on paraffin-embedded tissue from all patients. In addition, EBV strain typing and detection of the characteristic 30-bp deletion of the latent membrane protein-1 (LMP-1) gene were performed by PCR. Controls included 8 cases of uncomplicated infectious mononucleosis (IM). Patients included 4 males and 2 females with a median age of 18 years (2-37 years). Three patients were Mexican, 2 were white, and 1 was of Asian descent. All presented with fever, hepatosplenomegaly, and pancytopenia; 5 were previously healthy, but had a clinical history of a recent viral-like upper respiratory illness (1 week to 2 months), and 1 patient had documented chronic active EBV infection for 7 years. Serologic data for EBV were incomplete but titers were either negative or only modestly elevated in 3 cases. In 1 case serology was consistent with severe chronic active EBV infection. In the remaining 2 cases serologic studies were not performed. All patients died within 7 days to 8 months of presentation with T-cell LPD. On histologic examination, the liver and spleen showed prominent sinusoidal and portal lymphoid infiltrates of CD3+, βF1+, EBER1+ T cells lacking significant cytologic atypia. Two cases were CD4+, 2 cases were CD8+, and 2 cases had admixed CD4+ and CD8+ cells without clear subset predominance. All were TIA-1+, CD56−. Only rare B cells were noted. Marked erythrophagocytosis was present. Molecular analysis revealed identical T-cell clones in 2 or more sites (liver, spleen, lymph node) in 5 cases. All patients carried type A EBV; 4 cases had wild-type EBV-LMP, and 2 showed the 30-bp deletion. This fulminant T-cell LPD after acute/chronic EBV infection is characterized by hepatosplenomegaly, often without significant lymphadenopathy, fever, liver failure, pancytopenia, and erythrophagocytosis indicative of a hemophagocytic syndrome. EBV serology may be misleading, with lack of elevated titers. The presence of an EBER1+ T-cell infiltrate with scant B cells should alert one to this diagnosis. Although cytologic atypia is minimal, studies for T-cell clonality confirm the diagnosis.
Epstein-Barr virus (EBV) infection commonly occurs in early childhood. Primary infection is usually asymptomatic, but some children and, more often, adolescents and young adults develop infectious mononucleosis (IM).1 IM is a benign self-limited disease and results in a polyclonal B-cell proliferation secondary to the EBV infection. Although a strong antibody response to EBV occurs, the infection is controlled by an antigen-specific major histocompatibility complex-restricted cytotoxic T-cell response.2,3 Fatal IM (FIM) is an uncommon presentation of primary infection and is characterized by an uncontrolled B-cell lymphoproliferation due to a defect in T cell-mediated immune regulation.4-7 The necrosis observed in various organs in these patients has been attributed to the defective or imbalanced cytotoxic T-cell response, as well as the vascular damage mediated by chemokines.8,9 There is a high incidence of FIM in patients with X-linked lymphoproliferative disease (XLP, Duncan disease), which recently has been linked to mutations in the SH2-domain encoding gene.10 FIM also occurs sporadically; the clinical presentation in these cases is similar to that of Duncan disease, suggesting similar vulnerability.8 Histiocytic hyperplasia with erythrophagocytosis is a frequent finding in FIM, and a full-blown virus-associated hemophagocytic syndrome (VAHS) develops in 80% of the cases of FIM.4 EBV is the virus most frequently found in VAHS, which occurs primarily in immunosuppressed patients and usually has a fatal outcome, unless the immunosuppression can be reversed.4,7,8 11
Infection with EBV also has been implicated in the development of a variety of malignancies including Burkitt lymphoma,12B-cell lymphoproliferative disorders (LPDs) associated with severe immunodeficiency,13,14 Hodgkin disease,15-17certain types of T- and natural killer (NK)-cell lymphomas,18-20 nasopharyngeal carcinoma,21gastric carcinoma,22 and smooth muscle tumors in immunosuppressed patients.23 24 Most EBV+malignancies occur many years after primary EBV infection in a latently infected EBV+ cell.
Among the T-cell lymphomas associated with EBV25 are some cases that appear to develop as a direct complication of EBV infection, usually in the setting of severe chronic active EBV infection (SCAEBV).8,26-32 In addition, there are sporadic reports of a less well-characterized fulminant T-cell LPD that develops shortly after primary, acute EBV infection. Virtually all cases of the latter disorder have been reported in Asian children and detailed evaluation of the cell type infected and clonality has been performed only in some of these cases.33-41 The clinical presentation of this fulminant T-LPD shows significant overlap with FIM, and its relationship to classic FIM remains undefined.
In this study, we report the clinicopathologic features of 5 patients with a fulminant T-LPD that arose in the setting of acute primary infection and was characterized by a monoclonal proliferation of EBV-infected T cells. A 6th patient developed a similar syndrome following SCAEBV infection.
Materials and methods
All cases were reviewed at the Hematopathology Section, National Cancer Institute, National Institutes of Health, during the 1997-1999 period. Formalin-fixed, paraffin-embedded tissue blocks of liver, spleen, and lymph node biopsies were available for evaluation. Clinical information was obtained from the referring pathologists, as well as clinicians. Hematoxylin and eosin-stained slides and immunoperoxidase studies were reviewed in all cases by L.Q-M., S.K., and E.S.J.
Formalin-fixed, paraffin-embedded tissue blocks from 8 biopsies from patients with documented IM were used as controls. The tissues analyzed included 4 lymph nodes, 3 tonsils, and 1 nasopharyngeal lymphoid tissue.
Immunophenotypic studies
Immunohistochemical studies were performed using formalin-fixed, paraffin-embedded tissue sections on an automated immunostainer (Ventana Medical Systems, Tucson, AZ) according to the company's protocol with slight modifications. The antibody panel used included leukocyte common antigen (LCA, CD45, Dako, Carpinteria, CA), L26 (CD20, Dako), LeuM1 (CD15, Becton Dickinson, San Jose, CA), CD30 (CD30, Novocastra, Newcastle, UK), Leu 22 (CD43, Becton Dickinson), anti-CD3 (Dako), UCHL-1 (CD45RO, Dako), A6 (CD45RO, Zymed, San Francisco CA), CD4 (Novocastra), CD8 (Novocastra), CD56 (Novocastra), TIA-1 (Coulter, Miami, FL), and βF1(Dako). All biopsies were evaluated for the presence of EBV latent membrane protein 1 (LMP-1, Dako).
In situ hybridization for EBV
In situ hybridization (ISH) for EBV early RNA-1 (EBER1) was performed on fixed paraffin-embedded sections as previously described.42 The ISH procedure was carried out under RNAse-free conditions and the EBER1 riboprobe was prepared as previously described.42 The integrity of the RNA in each tissue was evaluated with U6, a cellular RNA polymerase III transcript (gift from Dr Richard Ambinder). Double staining for ISH and immunohistochemistry were performed following the above-described methods. ISH was performed first, followed by immunohistochemistry in the automated immunostainer.
Molecular genetic studies
Genomic DNA was extracted from paraffin blocks from all cases. This purified DNA was used to assay for clonal rearrangements of the immunoglobulin heavy chain (IgH) genes and the T-cell receptor (TCR) γ genes by polymerase chain reaction (PCR).43,44 PCR analysis for the 30-bp LMP gene deletion was performed using 2 20-base oligonucleotide primers flanking the characteristic 30-bp deletion, as described previously.45 The deletion mutant was initially suggested to be associated with a longer half-life and greater transforming potential. The specific amplified fragment length is 161 bp for the wild-type gene and 131 bp for the deletion variant. Identification of type A and type B strains of EBV was accomplished by the use of oligonucleotide primers flanking a region of the EBNA-2 gene as published previously.46 The expected fragments are 168 bp for EBV type A and 184 bp for EBV type B.
Results
Clinical findings
The clinical features of the cases are summarized in Table1. Three of the patients were Mexican, 2 were white, and 1 was of Asian origin. All patients were previously healthy, without opportunistic infections or other indications of any congenital immunodeficiency,nor had they received immunosuppressive medications. Five patients presented with the acute onset of fever and general malaise suggestive of a viral upper respiratory illness, whereas the 6th patient had documented CAEBV infection for 7 years before development of the T-cell LPD. Within a period of 1 week to 2 months all patients developed hepatosplenomegaly and jaundice without or with minimal lymphadenopathy. Laboratory tests showed pancytopenia (white blood cell count, 0.7-2.6 × 109/L; hemoglobin 76-87 g/L; platelets, 21-72 × 109/L) and abnormal liver function tests (total bilirubin, 51-205 μmol/L; aspartate transaminase, 336-487 U/L; alanine transaminase, 78-248 U/L). In 2 cases a diagnosis of viral hepatitis was considered, and in 1 case a diagnosis of thrombotic thrombocytopenic purpura was considered. EBV serology was available in 4 patients. In cases 1 and 5 EBV antiviral capsid antigen (anti-VCA) IgG titers were positive in the absence of anti-VCA IgM antibodies. In case 6 titers were indicative of SCAEBV infection. In case 3 serologic tests for EBV were negative (Table 1). EBV serology was not performed in cases 2 and 4; however, the acute onset of the disease in previously healthy individuals and the demonstration of EBV in the neoplastic cells were compatible with a recent infection with EBV. Antibodies to hepatitis viruses and cytomegalovirus were negative in all patients (data not shown).
Histologic findings
All cases showed essentially similar histologic findings in the liver and spleen. The splenic white pulp was inconspicuous to markedly depleted, whereas the sinusoids showed a prominent lymphoid infiltration (Figure 1A). There was striking hemophagocytosis within the splenic sinusoids (Figure 1B). The infiltrating lymphocytes were small and lacked significant cytologic atypia (Figure 1B). Immunoblasts and plasma cells were not prominent. The liver had prominent portal as well as sinusoidal infiltrates of small lymphocytes morphologically identical to those noted in the spleen (Figure 2). There was intracellular and intracanalicular cholestasis, steatosis, and focal necrosis. Hemophagocytosis was present within the sinusoids. In case 5, the spleen showed extensive areas of necrosis mainly in the perifollicular and periarteriolar lymphoid sheaths of the white pulp with the presence of immunoblasts reminiscent of IM.
Histologic findings in spleen.
(A) Section of spleen from case 2 shows depletion of white pulp and prominent sinusoidal small lymphoid infiltrates (hematoxylin and eosin, × 200). (B) The lymphocytes lack significant cytologic atypia. There is marked hemophagocytosis (hematoxylin and eosin, × 600).
Histologic findings in spleen.
(A) Section of spleen from case 2 shows depletion of white pulp and prominent sinusoidal small lymphoid infiltrates (hematoxylin and eosin, × 200). (B) The lymphocytes lack significant cytologic atypia. There is marked hemophagocytosis (hematoxylin and eosin, × 600).
Histologic findings in the liver.
(A) Liver specimen from case 1 shows prominent portal and sinusoidal lymphoid infiltrate (hematoxylin and eosin, × 200). (B) The infiltrating lymphocytes are small and lack cytologic atypia (hematoxylin and eosin, × 600).
Histologic findings in the liver.
(A) Liver specimen from case 1 shows prominent portal and sinusoidal lymphoid infiltrate (hematoxylin and eosin, × 200). (B) The infiltrating lymphocytes are small and lack cytologic atypia (hematoxylin and eosin, × 600).
The lymph nodes were largely unremarkable with preserved architecture and open sinuses. Hyperplasia of the follicular or paracortical compartment was lacking, and no immunoblastic reaction or necrosis was identified. A variable degree of sinus histiocytosis with erythrophagocytosis was present. Small granulomas were identified in 1 case (case 3). Bone marrow biopsies were available in cases 1, 2, 4, and 5 and showed histiocytic hyperplasia with prominent hemophagocytosis.
Immunophenotypic findings
The immunophenotypic features and molecular data are summarized in Table 2. Immunophenotyping was performed on the spleen or liver or both in all cases. The infiltrate in all cases was composed predominantly of CD3+ T cells (Figure3A). CD20 stained attenuated residual B-cell areas in the spleen and only rare scattered B cells were identified within the liver (Figure 3B). Staining for CD4 and CD8 showed that the infiltrate was CD8+ in 2 cases (Figure4A), CD4+ in 2 cases (Figure5A), and in the remaining 2 cases CD4+ and CD8+ cells were noted in approximately equal numbers without clear subset predominance. CD4 highlighted the erythrophagocytic histiocytes (Figure 4B). The lymphocytes in all cases expressed βF1 and TIA-1+ (Figure 4C and D) and were CD56−.
Liver infiltrate from case 1.
The infiltrating lymphocytes are predominantly CD3+ T cells (panel A), with only rare L26+ B cells (panel B) (immunoperoxidase stained, hematoxylin counterstained, × 200).
Liver infiltrate from case 1.
The infiltrating lymphocytes are predominantly CD3+ T cells (panel A), with only rare L26+ B cells (panel B) (immunoperoxidase stained, hematoxylin counterstained, × 200).
Staining for CD4 and CD8 in spleen from case 2.
(A) The lymphoid infiltrate in the spleen is predominantly CD8+. (B) Staining for CD4 highlights erythrophagocytic histiocytes, whereas the lymphocytes are negative. (C) The small lymphocytes express TIA-1. (D) They are BF1+ and are strongly EBER-1+ (E) (immunoperoxidase stained, hematoxylin counterstained, × 200).
Staining for CD4 and CD8 in spleen from case 2.
(A) The lymphoid infiltrate in the spleen is predominantly CD8+. (B) Staining for CD4 highlights erythrophagocytic histiocytes, whereas the lymphocytes are negative. (C) The small lymphocytes express TIA-1. (D) They are BF1+ and are strongly EBER-1+ (E) (immunoperoxidase stained, hematoxylin counterstained, × 200).
Staining for CD4 and CD8 in spleen from case 4.
(A) Low-power view of spleen shows that the lymphoid nodules are composed predominantly of CD4+ cells. (B) Relatively few CD8+ cells are seen. (C) The CD4+ cells are also EBER1+ (immunoperoxidase stained, hematoxylin counterstained, × 50).
Staining for CD4 and CD8 in spleen from case 4.
(A) Low-power view of spleen shows that the lymphoid nodules are composed predominantly of CD4+ cells. (B) Relatively few CD8+ cells are seen. (C) The CD4+ cells are also EBER1+ (immunoperoxidase stained, hematoxylin counterstained, × 50).
ISH for EBV
In situ hybridization for EBV using the EBER1 probe showed striking positivity in the majority of the small lymphoid cells in all cases (Figure 4E). Correlation of the EBV positivity with the distribution of CD4/CD8 staining clearly indicated that the EBV-harboring cells were CD8+ in cases 2 and 5 (Figure 4E) and CD4+ in case 4 (Figure 5A-C). In addition, although an admixture of CD4+ and CD8+ cells had been previously noted in case 1, double staining for EBER1 and CD4 confirmed presence of EBV in the CD4+ population, with the CD8+ cells being clearly negative (Figure 6A,B). In the other 2 cases (cases 3 and 6), it was difficult to ascertain whether the CD4+ or CD8+ cells harbored the EBV, and double staining was not contributory.
Double staining for CD4/EBER and CD8/EBER.
Double staining of the liver from case 1 shows that (A) the CD4+ population harbors the EBV, whereas (B) CD8+ population is clearly negative (EBER1 RNA ISH, immunoperoxidase stained with DAB chromogen, hematoxylin counterstained, × 600).
Double staining for CD4/EBER and CD8/EBER.
Double staining of the liver from case 1 shows that (A) the CD4+ population harbors the EBV, whereas (B) CD8+ population is clearly negative (EBER1 RNA ISH, immunoperoxidase stained with DAB chromogen, hematoxylin counterstained, × 600).
Molecular genetic studies
Analysis by PCR of paraffin-embedded tissue from the spleen, liver, or lymph nodes showed clonal rearrangements of the TCR-γgenes in 5 of the 6 cases (Figure 7A and B). Each of these cases exhibited bands of identical size at 2 or more involved sites. Case 4 showed a polyclonal population in both the liver and spleen. PCR for IgH gene rearrangements showed a polyclonal pattern in all cases.
PCR for TCR-γ gene.
PCR demonstrates an identical T-cell clone in the lymph node, liver, and spleen in case 2 (A) and in the lung, kidney, lymph nodes, liver, and spleen in case 6 (B) (ethidium-bromide-stained gel; p indicates positive control; mw, molecular weight size marker).
PCR for TCR-γ gene.
PCR demonstrates an identical T-cell clone in the lymph node, liver, and spleen in case 2 (A) and in the lung, kidney, lymph nodes, liver, and spleen in case 6 (B) (ethidium-bromide-stained gel; p indicates positive control; mw, molecular weight size marker).
Analysis by PCR for EBNA-2 indicated strain type A in all cases. PCR for the LMP gene showed a 161-bp size product in 4 cases, consistent with the wild type, whereas cases 3 and 5 showed a 131-bp product indicative of the 30-bp deletion (Figure 8A and B).
PCR for LMP gene.
(A) Strain typing for EBV using EBNA-2 primers demonstrates strain type A in all cases. (B) PCR analysis of the LMP-1 gene shows wild-type gene product (WT, 161 bp) in cases 1, 2, 6, 4. A deleted LMP-1 gene product (del, 131 bp) is noted in case 3; n indicates negative control).
PCR for LMP gene.
(A) Strain typing for EBV using EBNA-2 primers demonstrates strain type A in all cases. (B) PCR analysis of the LMP-1 gene shows wild-type gene product (WT, 161 bp) in cases 1, 2, 6, 4. A deleted LMP-1 gene product (del, 131 bp) is noted in case 3; n indicates negative control).
Immunophenotypic and molecular findings of control IM lymph nodes
In situ hybridization with the EBER1 probe revealed numerous positive cells, predominantly in the paracortical regions. Histologically, the EBER1+ cells corresponded to immunoblasts and were positive for L26. Molecular analysis of theTCR-γ genes and IgH genes showed a polyclonal pattern without evidence of clonal antigen-receptor gene rearrangement.
Discussion
We report 6 cases of fulminant T-cell LPD resembling FIM with VAHS, 5 following acute EBV infection in previously healthy individuals and 1 after SCAEBV. All cases progressed toward multiple organ failure, sepsis, and death. Central to the syndrome is a clonal systemic proliferation of morphologically innocuous appearing EBV-infected T cells with an activated cytotoxic phenotype (TIA-1+) expressing either CD4 or CD8. All patients carried type A EBV; 4 cases had wild-type EBV-LMP, and 2 cases carried the 30-bp deletion.
In individuals with a normal immune system, sustained T-cell infection by EBV occurs only rarely, raising the possibility that the infection of T lymphocytes and their subsequent unregulated growth is due, at least in part, to a defect in immune surveillance. In patients with no previously impaired immunity, the development of an acute T-cell LPD suggests a specific vulnerability to EBV. The short time from an apparent primary viral infection to the development of a T-cell LPD in 5 of the cases in this study is similar to what has been described in other EBV-induced LPDs in immunocompromised patients who develop B-cell proliferation, mainly in the post- transplantation setting.8 However, this has rarely been described to occur in T-cell LPD.
Our review of previously reported cases of acute T-cell LPD following primary infection with EBV showed that 9 of those 11 cases were Asian (Table 3).33-41 The remaining 2 were reported from Western countries, but their ethnic origins were not specified. The clinicopathologic features of these cases closely resemble ours. Most of the cases were initially diagnosed either as FIM or as VAHS. Seven cases had a CD8+ phenotype, 1 a NK phenotype, and 1 an admixture of CD4+ and CD8+ cells; in 1 case the T-cell phenotype could not be determined; and in 2 CD45RO+ cases the CD4/CD8 phenotype was not performed. All cases were monoclonal, demonstrated either by TCR gene rearrangement or clonality of the EBV genome.33-35,37,38,41 The clinical courses were fulminant with 10 patients dying within 3 days to 13 months (mean, 33 days) of the diagnosis. Interestingly, a relatively common finding in these patients was the lack of elevated antibody titers, or, in some cases, the total absence of serologic responses to EBV.33,36,38,40In our cases, serologic studies were incomplete or had not been performed. EBV IgM anti-VCA was negative in the 3 cases where it was evaluated. EBV IgG anti-VCA titers were only modestly elevated in 2 of these 3 cases. However, the abrupt/precipitous onset of symptoms in previously healthy individuals, as well as the widespread systemic infiltration of numerous EBV+ T cells was suggestive of an acute process. EBV serology in such cases, therefore, may be clinically misleading in that it does not suggest acute primary or active infection. This apparent lack of humoral response to the virus might increase the risk for T-cell infection and the subsequent monoclonal expansion. Recently, monoclonal and oligoclonal expansion of peripheral blood CD8+ T cells has been described in acute IM.3 These clonal populations are antigen driven and self-limited and disappear after resolution of the acute infectious process. Whether these expanded T-cell populations harbor EBV has not been investigated.3 Nevertheless, it is possible that in vulnerable patients the expanded T-cell populations become infected with EBV, triggering progression into a LPD. This sequence may be similar to what has been described in EBV related B-cell proliferations: (1) benign restricted lymphoid expansion; (2) an oligoclonal phase; and (3) a clonal neoplastic proliferation.
The differential diagnosis between FIM and fulminant T-cell LPD is difficult both on clinical and morphologic grounds. In fact, fulminant T-cell LPD, because of its presentation in many instances shortly after primary infection with EBV, could well be considered a manifestation of FIM. In other words, the clinical syndrome of FIM could be the end result of either an uncontrolled polyclonal B-cell LPD (classical form) or a monoclonal proliferation of activated cytotoxic T cells (TIA-1+) of either CD4 or CD8 phenotype. The reason(s) why some patients preferentially develop one type or the other have yet to be determined; however, ethnic factors seem to play an important role.
Morphologically, both FIM and fulminant T-cell LPD can show destruction of normal architecture with areas of necrosis. However, in classical FIM plasma cells and B immunoblasts predominate, even though they are often intimately associated with CD8+ T cells.4,5 Many of these B cells are EBER1+. In most cases immunophenotypic studies suggest a polyclonal proliferation of B cells and cases evaluated at the genotypic level have failed to show evidence of monoclonality for in genes for heavy chain and TCR.7,8,47 Likewise, the 8 cases of IM used as controls in this study revealed polyclonal B- and T-cell populations. Nevertheless, studies of tissues of patients with FIM suggest that some of the cases were in transition or had already evolved to a monoclonal B-cell lesion.6 48 In contrast, in fulminant T-cell LPD, B cells are rarely identified and it is the small to medium-sized T lymphocytes that harbor the EBV. Immunohistochemical analysis, ISH, and molecular biologic studies are therefore necessary to make a diagnosis of fulminant T-cell LPD. Given the close clinical similarity between these 2 disorders, and also because not every case diagnosed as FIM has been studied phenotypically and genotypically, we believe that some cases diagnosed as “classical” FIM in the past may actually represent fulminant T-cell LPD. Our study and other previously reported cases indicate that fulminant T-cell LPD is a malignant condition. We were able to demonstrate an identical T-cell monoclonal population in 2 or more different tissues in 5 of 6 cases. Although monoclonality developing during primary viral infection is an unexpected finding, it is known to occur as an early event in immunocompromised patients who develop B-cell LPD.
Clinical disorders that have overlapping features with fulminant T-cell LPD are the so-called fulminant hemophagocytic syndrome of children in Taiwan49 and fatal EBV-associated hemophagocytic syndrome in Japan.50 The cases reported by Su et al49 included 15 previously healthy children, 13 of whom had evidence of primary or acute infection with EBV. In 9 of these 13 cases EBER1 transcripts were identified exclusively within the T cells. However, determination of T-cell clonality was not performed. The study by Kikuta et al50 included 6 previously healthy children, 5 of whom had serologic evidence of primary EBV infection. A monoclonal or biclonal proliferation of the EBV-infected cells was shown in 3 of these cases using the terminal repeat analysis; however, the phenotype of the proliferating cells was not specified. Although these 2 previous studies lack important information, the similarities of these 2 syndromes with fulminant EBV+ T-cell LPD suggest that these disorders probably represent the same entity.
Another finding of interest in the present study is the fact that 3 of the patients were Mexican and 1 was of Asian descent. Other EBV-associated neoplasms such as NK/T- cell nasal lymphomas and EBV+ Hodgkin disease have been reported to be more prevalent in Latin American and Asian countries than in Western populations.18,51-53 One can speculate that the high prevalence of EBV-associated disorders in Asian and Mexican populations is due to a genetically determined susceptibility, possibly based on certain HLA types that result in an abnormal response to primary EBV infection.54,55 All the cases in this series carried type A EBV, similar to what has been described in posttransplant lymphomas.56 57
In the current series we encountered a single case of fulminant T-cell LPD that developed in the setting of SCAEBV, which had been present for several years before the development of the T-cell LPD. Notably, the first description of an EBV-associated T-cell lymphoma was in the setting of SCAEBV,26 and reports of other similar cases have followed (Table4).26-32,58,59 Interestingly, most of the patients reported in the literature have been Japanese children. Our patient was a white girl who presented mainly with liver involvement. Although this case arose in the setting of chronic EBV infection, the terminal event represented a fulminant systemic illness similar to our other cases. The pathogenic mechanism(s) responsible for the development of T-cell LPD in SCAEBV remains unclear. Patients with SCAEBV are thought to have a defective EBV-specific cytotoxic T lymphocyte activity with an abnormal immunologic response to the virus.27,58 Both the acute and chronic cases appear to share this defect in immune surveillance. Recently, EBV-carrying T-cell lines were established from cultures of peripheral blood lymphocytes from 3 patients with SCAEBV.59 This finding, together with the demonstration of infected CD4+ T lymphocytes in the peripheral blood of 2 Japanese patients with SCAEBV before the development of a T-cell lymphoma,30 strongly suggests that the infection of reactive T cells might be important not only for the pathogenesis of SCAEBV, but also for the development of the subsequent EBV-associated T-cell lymphoma.
In conclusion, fulminant EBV+ T-cell LPD is a life-threatening illness that should be considered in the recently recognized spectrum of EBV-related T-cell LPD. It can occur in the setting of an apparent primary EBV infection, or more rarely, is associated with SCAEBV infection. An underlying or acquired defect in the immune response to EBV may be common to both groups, and in both groups evidence of racial predisposition is seen, suggesting that this is a single disorder. Whether the lymphoproliferation represents an aberrant clonal expansion similar to some of the B-cell LPD in patients after transplant or a true malignant neoplasia may be a matter of controversy. An important pitfall in the diagnosis is the lack of serologic evidence supporting acute primary or active EBV infection. Furthermore, some cases of FIM and VAHS described in the past, may actually be examples of this disorder.
Acknowledgments
We would like to thank Dr Adriana Marques and Ms Janet Dale, Laboratory of Clinical Investigation, Institute of Allergy and Infectious Diseases, NIH, Bethesda, MD for the clinical care of patient 6. We also wish to thank Dr Lisa DiFrancesco, Dr Fontanive, Dr T. Moulton, and Dr C. J. Cold for referring the other cases and providing clinical information. We thank C. Harris and S. Delay for their expert help with immunohistochemistry.
Supported in part by the Austrian Science Fund Charlotte-Bühler Habilitationstipendium (L.Q.-M.) and Erwin Schrödinger-Stipendium (F.F.). This research was presented, in part, at the 88th Annual Meeting of the United States and Canadian Academy of Pathology, San Francisco, CA, March 1999.
L.Q.-M. and S.K. contributed equally to this work.
Reprints:Elaine S. Jaffe, Building 10, Room 2N202,10 Center Drive, MSC 1500, National Cancer Institute, National Institutes of Health, Bethesda, MD 20892-1500; e-mail: elsjaf@box-e.nih.gov.
The publication costs of this article were defrayed in part by page charge payment. Therefore, and solely to indicate this fact, this article is hereby marked “advertisement” in accordance with 18 U.S.C. section 1734.